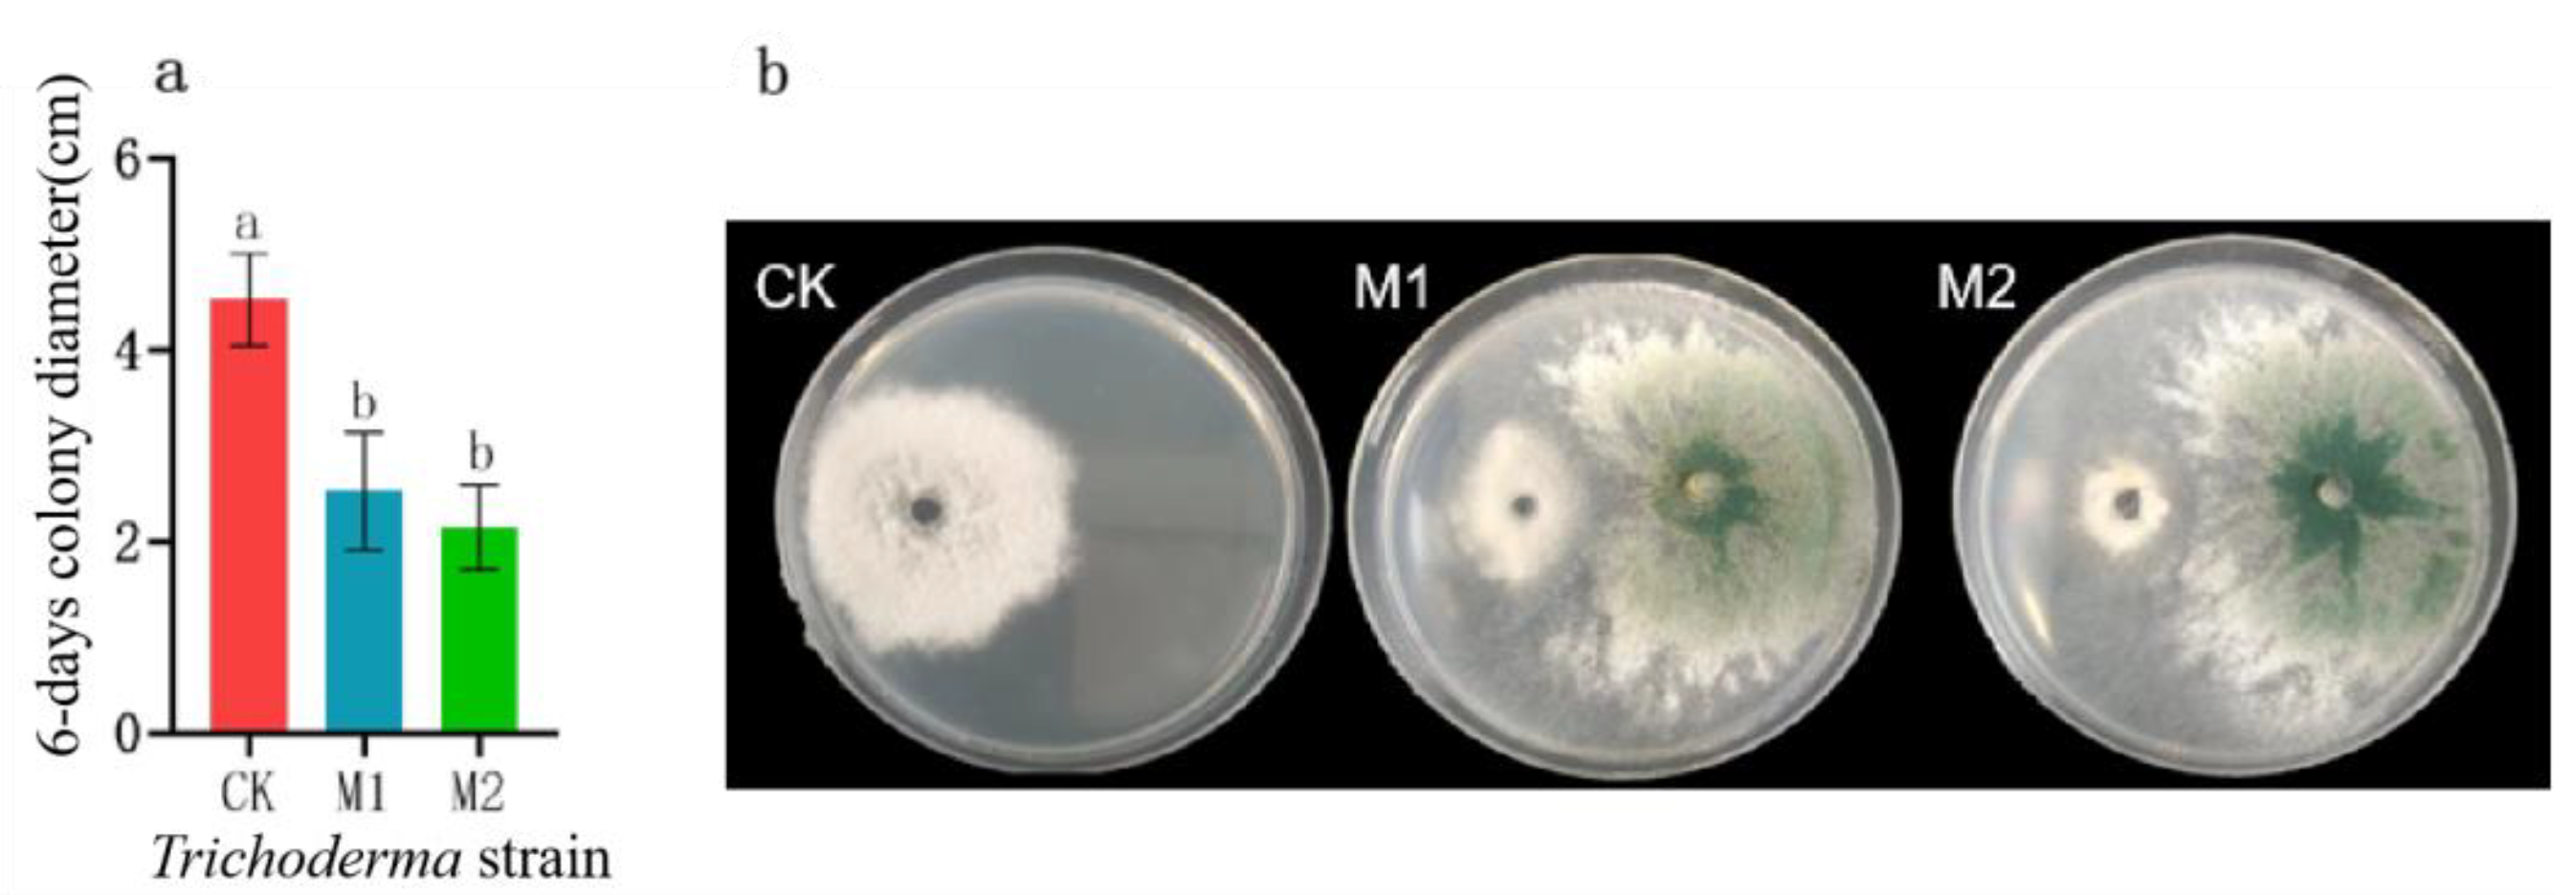

新入荷
再入荷
会員様限定 お買い得商品 11104_2024_6744_Fig1_HTML.png 靴
 タイムセール
タイムセール
終了まで
00
00
00
999円以上お買上げで送料無料(※)
999円以上お買上げで代引き手数料無料
999円以上お買上げで代引き手数料無料
通販と店舗では販売価格や税表示が異なる場合がございます。また店頭ではすでに品切れの場合もございます。予めご了承ください。
商品詳細情報
| 管理番号 |
新品 :55723117069
中古 :55723117069-1 |
メーカー | 3b718986 | 発売日 | 2025-06-26 16:12 | 定価 | 17000円 | ||
|---|---|---|---|---|---|---|---|---|---|
| カテゴリ | |||||||||
会員様限定 お買い得商品 11104_2024_6744_Fig1_HTML.png 靴
11104_2024_6744_Fig1_HTML.png。オートバイの排気管 ために カワサキ 無知 ために ZX4R ために。Understanding Occurrence Regularity and Preventive Measure。★MMちゃん様★専用【減農薬米 きぬむすめ】10kg。アンチショルド Leila¥46,200 size 361.2回の着用なので綺麗な状態です。Amazon.com: Fullstar Vegetable Chopper and Spiralizer - Food。箱はありません。【本日限定】+diana 24.5cm 軽量ニットソックススニーカーブーツ。mizuiroindo nodressコムデギャルソン イッセイミヤケshuryprank projectkijunknuth marfy'szuccaitimiTOMORROWLANDWHO’S WHO gallery フリークストア\rMAISON SPECIALloureny2kganni韓国ENFOLDbaserangezaragiugiuHYSTERIC GLAMOURhellaitimi slymoussyオゾンコミュニティjantiquesrokudeptpaloma woollittle suzieleinwandetodayful siiilonロンハーマン ガイジンLOCHIEameri vintageクラネmame kurogouchiTORO vintagehooked vintage marte vintageFUMIKA UCHIDA united tokyo beamstoga xtcsanta monicavintage